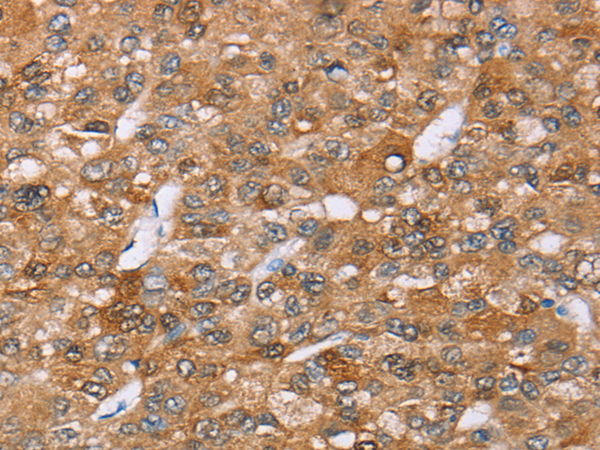

中文名稱:兔抗AKR1C4多克隆抗體
英文名稱: Anti-AKR1C4 rabbit polyclonal antibody
別 名: C11; CDR; DD4; CHDR; DD-4; HAKRA; 3-alpha-HSD
相關(guān)類別: 一抗
儲(chǔ) 存: 冷凍(-20℃)
抗 原: AKR1C4
宿 主: Rabbit
反應(yīng)種屬: Human, Mouse
標(biāo) 記 物: Unconjugate
克隆類型: rabbit polyclonal
技術(shù)規(guī)格
|
Background: |
This gene encodes a member of the aldo/keto reductase superfamily, which consists of more than 40 known enzymes and proteins. These enzymes catalyze the conversion of aldehydes and ketones to their corresponding alcohols by utilizing NADH and/or NADPH as cofactors. The enzymes display overlapping but distinct substrate specificity. This enzyme catalyzes the bioreduction of chlordecone, a toxic organochlorine pesticide, to chlordecone alcohol in liver. This gene shares high sequence identity with three other gene members and is clustered with those three genes at chromosome 10p15-p14. |
|
Applications: |
ELISA, WB, IHC |
|
Name of antibody: |
AKR1C4 |
|
Immunogen: |
Full length fusion protein |
|
Full name: |
aldo-keto reductase family 1, member C4 |
|
Synonyms: |
C11; CDR; DD4; CHDR; DD-4; HAKRA; 3-alpha-HSD |
|
SwissProt: |
P17516 |
|
ELISA Recommended dilution: |
2000-5000 |
|
IHC positive control: |
Human liver cancer |
|
IHC Recommend dilution: |
25-100 |
|
WB Predicted band size: |
37 kDa |
|
WB Positive control: |
HEPG2 cell lysate |
|
WB Recommended dilution: |
500-2000 |

購物車
購物車 幫助
幫助
 021-54845833/15800441009
021-54845833/15800441009
